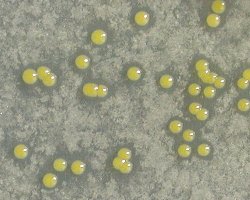

Sphingobium japonicum UT26S (= NBRC 101211)
γ-Hexachlorocyclohexane (γ-HCH) is a halogenated organic insecticide, which was once used widely throughout the world, but has been prohibited in many countries.
Use of γ-HCH causes serious environmental problems because of its toxicity and long persistence in upland soil. Sphingobium japonicum UT26S utilizes γ-HCH as the sole source of carbon and energy under aerobic conditions1, 2. Fifteen lin genes involved in γ-HCH degradation has been identified3, 4, 5.
Sphingomonas-related strains are well known to degrade wide range of natural and xenobiotic compounds, such as chlorinated phenols, polychlorinated biphenyls and azo dyes. This suggests that the Sphingomonas strains have the ability to adapt environments probably by degrading compounds.
Genome analysis of S. japonicum UT26S revealed 5 replicons composed of two circular chromosomes, chromosome 1 (3,514,822 bp, 64.8 % G+C, 3,529 ORFs), chromosome 2 (681,892 bp, 65.9 % G+C, 589 ORFs) and three circular plasmids, pCHQ1 (190,974 bp, 63.0 % G+C, 224 ORFs), pUT1 (31,776 bp, 63.7 % G+C, 44 ORFs) and pUT2 (5,398 bp, 61.0 % G+C, 8 ORFs). Thelin genes involved in the degradation of gamma-HCH was dispersed upon 2 chromosomes and a large plasmid. Comparison of S. japonicum UT26S genome with those of other Sphingomonadaceae strains demonstrated that about a half of lin genes were located on S. japonicum UT26S specific regions, and remaining half were embedded in conserved core regions among sphingomonad strains. These results proposed the hypothesis that lin genes were gradually acquired by S. japonicum UT26S in the course of environmental adaptation.
The genome sequence of S. japonicum UT26S should provide insights for abilities and adaptation mechanisms of pesticide degrading bacteria.
Sphingobium japonicum UT26S photo by Dr. Nagata in Tohoku University.
References:
- [1] Dehydrochlorination of γ-Hexachlorocyclohexane (γ-BHC) by γ-BHC-Assimilating Pseudomonas paucimobilis
- Imai,R, Nagata Y, Senoo K, Wada H, Fukuda M, Takagi M and Yano K. (1989)
Agric. Biol. Chem.53:2015-2017. - [2] Hexachlorocyclohexane-degrading bacterial strains Sphingomonas paucimobilis B90A, UT26 and Sp+, having similar lin genes, represent three distinct species, Sphingobium indicum sp. nov., Sphingobium japonicum sp. nov. and Sphingobium francense sp. nov., and reclassification of [Sphingomonas] chungbukensis as Sphingobium chungbukense comb. nov.
- Pal R, Bala S, Dadhwal M, Kumar M, Dhingra G, Prakash O, Prabagaran SR, Shivaji S, Cullum J, Holliger C and Lal R. (2005)
Int. J. Syst. Evol. Microbiol. 55:1965-1972. [PMID:16166696] - [3] Identification and characterization of genes involved in the downstream degradation pathway of gamma-hexachlorocyclohexane in Sphingomonas paucimobilis UT26.
- Endo R, Kamakura M, Miyauchi K, Fukuda M, Ohtsubo Y and Tsuda M. (2005)
J. Bacteriol. 187:847-853. [PMID:15659662] - [4] Identification and characterization of genes encoding a putative ABC-type transporter essential for utilization of gamma-hexachlorocyclohexane in Sphingobium japonicum UT26.
- Endo R, Ohtsubo Y, Tsuda M and Nagata Y. (2007)
J. Bacteriol. 189:3712-3720. [PMID:17369300] - [5] Aerobic degradation of lindane (γ-hexachlorocyclohexane) in bacteria and its biochemical and molecular basis.
- Nagata Y, Endo R, Ito M, Ohtsubo Y, Tsuda M. (2007)
Appl Microbiol Biotechnol. 76:741-52. [PMID:17634937]
| chromosome 1 | chromosome 2 | pCHQ1 | pUT1 | pUT2 | |
|---|---|---|---|---|---|
| Genomic size: | 3,514,822 bp | 681,892 bp | 190,974 bp | 31,776 bp | 5,398 bp |
| The number of ORFs: | 3,529 | 589 | 224 | 44 | 8 |
| GC content: | 64.8% | 65.9% | 63.0% | 63.7% | 61.0% |
| Genome Database: | DOGAN | ||||
| NBRC* No. : | 101211 | ||||
- *:
- NBRC is the acronym for "the NITE Biological Resource Center".
The URL of NBRC is http://www.nbrc.nite.go.jp/e/index.html.
- Distribution of Our Microbial Genomic DNAs
- At the Biological Resource Center of the National Institute of Technology and Evaluation (NITE Biological Resource Center, an Incorporated Administrative Agency), we have been distributing the microbial genomic DNA.
Contact us
- Biotechnology Evaluation and Development Division, Biological Resource Center, National Institute of Technology and Evaluation
-
Address:2-49-10 Nishihara, Shibuya-ku, Tokyo 1510066, Japan MAP
Contact Form


